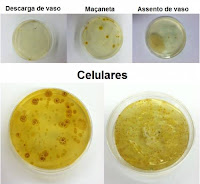

quinta-feira, 26 de abril de 2012
Que tal um carregador que mata as bactérias do seu celular?
por Olhar Digital
Não é de hoje que estudos científicos têm comprovado o quanto muitos usuários não higienizam os próprios gadgets. No Reino Unido, por exemplo, um em cada seis celulares contém coliformes fecais, e o mouse de computador tem mais germes que um vaso sanitário.
No entanto, um novo projeto postado no site de startups Kickstarter promete ser uma solução muito útil na vida dos viciados em telefonia móvel: é o PhoneSoap, um dispositivo no formato de uma pequena caixa de metal prateada que esteriliza até micro-organismos invisíveis com a ajuda de uma luz ultravioleta. O melhor é que, enquanto realiza essa limpeza, o produto também funciona como um carregador de bateria.
Entre 3 e 5 minutos, qualquer bactéria ou vírus presente na superfície do celular são mortos. Vale lembrar que o periférico não gera nenhum calor extra e não danifica o funcionamento do telefone.
O aparelho ainda está em estágio de desenvolvimento, e deverá custar US$ 39 (R$ 72 na cotação atual).
Para provar a utilidade do PhoneSoap, os inventores coletaram amostras de diversos banheiros e compararam com a superfície dos celulares. Veja na imagem abaixo:
Lenovo lidera crescimento no mercado de PCs
Segunda maior fabricante de computadores do mundo, a Lenovo é a líder isolada no crescimento do mercado de PCs. Segundo a IDC, a empresa registrou um aumento de 43,7% no primeiro trimestre do ano em relação a 2011.
Com 11,7 milhões de computadores vendidos e 13,4% de participação, a empresa se consolidou como a que mais cresce pelo 10º semestre consecutivo e chega mais perto da HP, que apresentou um crescimento de apenas 3,2%. A Dell, terceira colocada do ranking, sofreu queda de 2,1%.
Ainda de acordo com o estudo, o crescimento acima de 40% da empresa chinesa ficou acima da média do mercado e dos concorrentes. “Os resultados divulgados pela IDC afirmam novamente o trabalho comprometido e de qualidade feito pela Lenovo, em todas as regiões”, afirma Humberto De Biase, diretor de Marketing da Lenovo.
O período superou as expectativas da consultoria, com um aumento de 2,3%, enquanto as projeções apontavam 0,9% devido às condições instáveis da economia, competição entre os computadores pessoais e outros dispositivos, além das incertezas pelo Windows 8.
Desktop perde espaço para laptop e tablet
A preferência dos consumidores em 2012 será por laptops e tablets. Pesquisa do IBOPE Inteligência, em parceria com a Worldwide Independent Network of Market Research (WIN), mostra que 32% dos consumidores no mundo todo têm a intenção de comprar um laptop, 24% manifestam a intenção de comprar um tablet e 22% demonstram interesse em adquirir um desktop.
A Dell é a marca preferida tanto para laptops (18%) como para desktops (15%), seguida da Apple (16% e 13%, respectivamente), HP (13% nas duas categorias), Acer (9% e 6%, respectivamente) e Samsung (7% e 6%, respectivamente). No Brasil, Apple e LG dividem as intenções de compra de laptops. Em segundo, empatam Samsung e Dell e, em terceiro, Acer e HP.
No mercado de tablet, a marca criada por Steve Jobs também lidera. Quase metade (47%) dos consumidores pretende adquirir um tablet da Apple. Samsung tem 12% das intenções, Dell, 4%, e Amazon, Sony e RIM/BlackBerry, 3% cada.
A posse de laptops em 2011 ficou praticamente estável no mundo todo, passando de 60% em 2012 para 59% no ano passado. Já a posse de desktops apresentou queda no mesmo período, de 73% para 68%. No Brasil, em 2011, a posse de desktops foi de 37%, enquanto a de laptops, 16%.
O estudo ouviu 40.557 pessoas em 44 países. No Brasil, foram 2.002 entrevistas em âmbito nacional, com homens e mulheres de 16 anos ou mais, das classes A, B, C, D e E (Critério Brasil). por adNEWS
Walmart passa a vender via celular
O site de comércio eletrônico do Walmart lançou sua plataforma mobile (m-commerce), amigável e de fácil navegação. Assim como o e-commerce do Walmart nos EUA, a subsidiária brasileira aposta em ações diferenciadas para a iniciativa, em parceria com a VTEX e Fingertips, empresa do Grupo.Mobi. Agora, o endereço walmart.com.br já pode ser acessado por qualquer smartphone.
“A compra no comércio eletrônico através de aparelhos móveis ainda é pouco representativa no Brasil, mas o crescimento é exponencial. Não temos dúvida de que é um processo irreversível e o lançamento dessa versão mobile é apenas o primeiro passo de várias novidades que pretendemos trazer aos clientes que optarem por nos acessar através de seus smartphones e tablets”, afirma Flávio Dias, vice-presidente do e-commerce do Walmart Brasil.
A nova plataforma apresenta estratégias diferenciadas, como a facilidade de navegação - o sistema de busca, por exemplo, é exatamente igual ao da loja virtual tradicional. Um dos destaques do m-commerce é a recuperação do carrinho de compras - quando o cliente interrompe o processo, ele recebe um e-mail que resgata os itens selecionados e avisa que a compra não foi finalizada.
O Grupo.Mobi criou a parte de usabilidade e design do projeto. “Desenvolvemos a estratégia e criamos toda a interface, wireframe e layout pensando no usuário, que poderá navegar pelo mobile site de forma simples e intuitiva. Além disso, o m-site segue as recomendações das melhores práticas de mobile commerce, que visam a melhor experiência possível ao usuário, independente do tipo da interface que ele utilizar”, afirma Flavia Biasotto, sócia-diretora de Atendimento do Grupo.Mobi. “Dessa forma, o consumidor se sente confortável para utilizar o m-site do Walmart e realizar as suas compras pelo celular.”
"O template móvel é utilizado por 95% dos usuários que acessam a partir de dispositivos mobile", completa Geraldo Thomaz, CEO da VTEX, responsável pela programação do m-commerce da rede. por adNews
Facebook pode lançar smartphone próprio após anunciar IPO
Mark Zuckerberg e HTC trabalham em conjunto no desenvolvimento do produto, já apelidado de 'Facebook Phone'
De acordo com o site Digitimes, o Facebook se prepara para fazer o lançamento de um celular próprio, com início das vendas após o anúncio de seu IPO, que acontece em junho.
A rede social está trabalhando em conjunto com a HTC no desenvolvimento do produto, já apelidado de "Facebook Phone". A ideia é que o aparelho tenha uma plataforma exclusiva para o Facebook e que permita que o usuário tenha acesso total às funcionalidades disponíveis na página do site de relacionamentos.
No entanto, esta não seria a primeira vez que a HTC lança um produto com características e funcionalidades específicas do Facebook. No ano passado, a empresa apresentou os smartphones "Salsa" e "Chacha", cujas funções eram integradas diretamente à rede social. A diferença é que, agora, Mark Zuckerberg está envolvido no processo de criação e produção do dispositivo, o que pode diferenciar o celular no mercado de telefonia móvel.
IPO bilionário
Prevista inicialmente para o meio de maio, a primeira oferta pública de ações da rede social pode acontecer apenas em junho. Os executivos da rede social estariam, no momento, mais interessados em outros investimentos, como a aquisição de companhias e de patentes, e acabaram se distraindo com a rotina de negócios. Por isso, não teriam se preocupado tanto com a entrada na bolsa.
Além disso, as recentes aquisições do Instagram e de patentes da Microsoft fazem com que a Comissão de Valores Mobiliários dos Estados Unidos precise de mais tempo para avaliar a situação dos negócios do Facebook, o que também contribui para o atraso da venda de papéis da empresa. Agora, o Facebook estaria trabalhando com algumas alternativas para a abertura de capital, que poderia acontecer entre o fim de maio e o meio de junho. Com a entrada na bolsa, o Facebook espera ser avaliado em até US$ 100 bilhões e pretende levantar US$ 10 bilhões para investimentos.
Senado tem nova proposta para ICMS no comércio eletrônico
:: Da redação* :: Convergência Digital :: 25/04/2012
O senador Renan Calheiros (PMDB-AL) apresentou nesta quarta-feira (25) substitutivo da matéria na Comissão de Constituição, Justiça e Cidadania (CCJ) às três propostas de emendas à Constituição relativas ao Imposto sobre Circulação de Mercadorias e Serviços (ICMS) do comércio eletrônico.
Hoje, o consumidor de um estado que adquirir produto pela internet em outra unidade da Federação, paga o ICMS na origem da mercadoria. A proposta do relator é sujeitar essas operações, em que o cliente não é inscrito no ICMS, ao mesmo tratamento dado às vendas que se realizam entre empresas de estados diferentes.
Quando a operação ocorrer entre pessoas jurídicas com inscrição no ICMS, aplicam-se duas alíquotas: a interestadual – paga à secretaria de fazenda da unidade federativa de origem – e a alíquota final, que cabe ao estado para onde a mercadoria se destina.
O substitutivo de Renan deixa claro que caberá ao estado de localização do destinatário da mercadoria o imposto correspondente à diferença entre a alíquota interna e a interestadual.
Equilíbrio
Conforme o relator, a mudança contribui para o equilíbrio entre as unidades federativas e terá grande impacto econômico – a estimativa é de que o comércio eletrônico movimentou R$ 18,7 bilhões no ano passado. Quando a atual regra foi colocada na Constituição, em 1988, e-commerce ainda nem existia.
Vários senadores elogiaram, na discussão da proposta na CCJ, a fórmula definida no substitutivo. Duas das propostas de emenda à Constituição – as PECs 56 e 113, de 2011, respectivamente de autoria dos senadores Luiz Henrique da Silveira (PMDB-SC) e Lobão Filho (PMDB-MA) – já previam a aplicação das alíquotas interestaduais no faturamento direto ao consumidor.
A diferença entre elas decorre da abrangência: enquanto a 56 trata especificamente de comércio eletrônico, a de 113 refere-se a todo o comércio interestadual, presencial ou não.
O que Renan Calheiros fez foi juntar um pouco das duas propostas, abrangendo o comércio eletrônico e o comércio feito de forma não presencial, como as encomendas por catálogo ou por telefone.
Repartição
A PEC 103/2011, de autoria do senador Delcídio Amaral (PT-MS), atribui a uma futura resolução do Senado a definição das alíquotas, propondo percentuais provisórios até que a norma seja editada. Delcídio quer que o estado destinatário da mercadoria fique com 70% do ICMS arrecadado nas operações “não presenciais”.
Hoje, produtos que saem dos estados mais desenvolvidos, ou seja, os das regiões Sul e Sudeste (exceto Espírito Santo), pagam na origem 7% do ICMS, que corresponde à alíquota interestadual. Os menos desenvolvidos, ou seja, os das regiões Norte, Nordeste e Centro-Oeste, mais Espírito Santo, ficam com uma alíquota interestadual de 12% do ICMS.
O consumidor, quando compra o produto em uma loja, paga embutido no preço a alíquota final, em torno de 17% (varia conforme o produto e pode chegar a 25%). O comerciante se credita da alíquota interestadual – já recolhida na origem – e paga apenas a diferença à secretaria da fazenda de seu estado.
A votação está marcada para a próxima quarta-feira (2) e, se a matéria for aprovada, segue para votação em dois turnos no Plenário do Senado.
*Fonte: Agência Senado
"MacBook Air está à frente de seu tempo", diz criador do Linux
da redação Macworld
O criador do sistema operacional livre Linux, Linus Torvalds, se define como um homem simples e pouco sofisticado, que "anda de meias e sandálias pela casa". Entretanto, uma de suas aquisições tecnológicas se tornou sua predileta: um MacBook Air da Apple.
Em um entrevista cedida ao Tech Crunch, o desenvolvedor soltou muitos elogios ao computador da Apple, e que o dispositivo se destaca mesmo quando comparado ao MacBook Pro. “O MacBook Air estava (e ainda está) à frente de seu tempo. Até mesmo os outros laptops da Apple podem parecer bonitos, mas são o mesmo hardware velho e sem sofisticação”, comentou.
Torvalds também comparou a companhia de Cupertino a suas concorrentes, apontando que, desde o lançamento do Air, os fabricantes têm tentado fazer algo parecido, contudo oferecem apenas opções “feias e barulhentas”. O criador do Linux ainda fez questão de destacar que a Apple não foi a criadora do conceito de notebooks finos e leves, porém a empresa foi quem o executou melhor até agora.
Com SSD (drive de estado sólido, em inglês), os novos modelos do MacBook Air da Apple possuem processadores mais poderosos, e até chegam a superar certas versões do MacBook Pro; a bateria do laptop também é poderosa, e chega a durar até 30 dias em modo standby. Outra vantagem é que o Air é mais leve e silencioso do que seus “irmãos maiores”, o que também foi apontado por Torvalds. “A coisa mais barulhenta do meu escritório deve ser o ronronar ocasional do meu gato. E quanto quero viajar, quero carregar pouco peso - notebooks com mais de um quilo simplesmente não são bons” concluiu o desenvolvedor.
Comparativo: Google Drive vs Dropbox vs SkyDrive...
Por Jared Newman, PC World / EUA 25-04-2012
O Google Drive, serviço de armazenamento online da Google, foi finalmente lançado após anos de rumores. E não é surpresa alguma ver que a concorrência está preparada. Serviços como o Dropbox e o Skydrive, da Microsoft, vem há algum tempo ganhando novos recursos, e já há algumas semanas venho recebendo e-mails de outros concorrentes, me lembrando de sua existência.
E como todos esses serviços se comparam ao novo Google Drive? Criamos uma tabela que mostra os principais recursos.
Além dela, vale a pena mencionar alguns destaques:
O SkyDrive oferece o maior espaço gratuito, 7 GB, e usuários que se registraram antes de 22 de Abril ganham 25 GB livres por tempo limitado.
O Google Drive supera todos os concorrentes no valor da mensalidade, mas o Skydrive, que cobra anuidade, é o mais barato quando consideramos o valor total ao longo de um ano.
O SugarSync é o único serviço que permite sincronizar qualquer pasta local com o espaço online, mas o SkyDrive oferece acesso remoto completo ao seu PC usando um sistema de autenticação em dois passos.
Cuidado com os limites no tamanho dos arquivos. O SugarSync não tem limite algum, e o limite de 10 GB por arquivo no Google Drive é muito mais generoso do que nos outros serviços.
Integração com aplicativos web e compartilhamento público e privado de arquivos são pontos chave no momento.
As opções do Google e Microsoft tem suas desvantagens: nenhuma suporta o sistema operacional móvel da concorrente (Android, da Google, e Windows Phone 7.5, da Microsoft)
Claro que uma simples lista de recursos pode não ser o suficiente para uma decisão. Você pode preferir o Dropbox porque há mais pessoas usando ele, ou o Google Drive porque você já usa muitos outros serviços do Google e quer consolidar o armazenamento online. Use nosso comparativo como um guia, e encontre o serviço que é mais adequado para você.
Segundo estudo, tablets dominarão mercado em quatro anos
Matt Hamblen, Computerworld
De acordo com analistas da Forrester, categoria alcançará vendas de 375 milhões de unidades em 2016. Estimativa é quase o dobro do previsto pela IDC
Os tablets vão se tornar o aparelho principal de computação para a maioria dos usuários nos próximos quatro anos, afirma o analista da consultoria Forrester Research, Frank Gillett. O especialista publicou ontem, 23/4, uma previsão de que 375 milhões de tablets serão vendidos no mundo em 2016. Esse prognóstico é quase duas vezes maior do que o previsto pela consultoria IDC, que afirma que veremos cerca de 200 milhões de tablets vendidos globalmente daqui a quatro anos.
Uma grande diferença no tamanho da previsão de Gillett é o quão central os tablets ficarão em muitos locais, incluindo o ambiente de trabalho, onde esses aparelhos são úteis para compartilhamento e trabalhos em grupo. “Não há barreira de uma tela vertical, nenhum barulho de teclado distraindo e simplesmente parece natural passar um tablet, como uma folha de papel, em comparação a ficar andando em volta de um notebook”, escreve o analista no seu blog. “Os tablets vão se tornar o aparelho principal e preferido de milhões de pessoas no mundo.”
Em 2016, um terço dos 375 milhões de tablets vendidos irão para usuários corporativos, afirma o especialista. Em comparação, as vendas de tablets totalizaram 56 milhões de unidades em 2011, de acordo com a Forrester.
A Forrester também prevê que a base de tablets vendidos alcance 760 milhões de unidades em 2016.
O analista da Forrester define um tablet como sendo um aparelho com capacidades touschreen (tela sensível ao toque), pesando menos de 800g com uma tela de tamanho entre 7 e 14 polegadas, com bateria de duração de oito horas pelo menos e funcionamento constante.
Mesmo com as vendas de tablets crescendo, eles vão apenas “canibalizar parcialmente os PCs”, escreveu Gillet. “Eventualmente, os tablets vão diminuir as vendas de laptops, mas aumentar as de PCs desktop.” Muitos profissionais de comunicação e tecnologia ainda precisarão de PCs convencionais para trabalhos criativos que exigem grande poder de processamento ou uma tela grande.”
Gillett também escreveu um relatório de 17 páginas junto com outros analistas da Forrester que descreveram maneiras pelas quais os tablets e smartphones se encaixarão em uma nova forma de computadores. Chamados de “frames”, esses novos PCs serão essencialmente telas com sensores, poder de processamento e dock wireless para funcionar com aparelhos móveis de todos os tipos.
Os frames ficarão localizados em salas de reunião, cafeterias e mais, prevê a Forrester. Os tablets usados com frames vão substituir os laptops em grande volume, aponta o relatório.
Os tablets se tornarão o aparelho central na computação pessoal porque são fáceis de usar e compartilhar; portáteis; possuem baterias que duram o dia todo; e são flexíveis tanto para consumo de conteúdo quanto para tarefas criativas e produtivas, aponta o relatório da Forrester.
Closed caption: saiba como funcionam as legendas automáticas nas TVs
Por Ana Ikeda Do UOL, em São Paulo
Na sala de espera do hospital, na padaria, no bar ou restaurante: você bate o olho na televisão e lá estão aquelas legendas automáticas – por vezes sem pé nem cabeça – mostrando o que é falado no programa exibido naquele momento. É o recurso “closed caption” ou legenda oculta. Como elas vão parar lá? Quem faz esses textos? Por que lemos tantos erros? Veja a seguir essas dúvidas e outras curiosidades respondidas:
Como as legendas são feitas?
Os textos são criados especialmente para pessoas com deficiência auditiva, então têm de descrever, além das falas, ruídos ou sons de plano de fundo. Tanto softwares especiais de reconhecimento de voz como “pessoas de carne e osso” podem transcrever esses textos.
Máquina: esse método é mais comum em programas gravados. O roteiro daquele filme ou episódio é usado para guiar o trabalho de quem faz a legenda. Quem legenda ouve o que é falado na cena e repete as frases devagar ao computador com software que reconhece voz. Além disso, o profissional insere as marcações de som (bater de palmas, risos, música de fundo). Cada hora de vídeo vira de 3 a 5 horas de trabalho para fazer o closed caption. Nos programas gravados, geralmente há revisão das legendas antes da digitalização.
Homem: esse método é mais comum em programas ao vivo. Um jornal, por exemplo, pode ser legendado de acordo com o fornecimento do texto do teleprompter (aparelho que mostra o que os apresentadores têm de narrar). Quando o repórter entra ao vivo, a legenda fica a cargo de um estenotipista (profissional que usa um estenótipo digital, máquina desenhada especialmente para a digitação rápida de palavras, com número reduzido de teclas, que envia as legendas direto ao computador). Muitas emissoras brasileiras utilizam essa técnica para programas gravados também.
Por que encontramos tantos erros nas legendas ocultas?
Nem sempre o software transcreve corretamente as palavras ditas e também há dificuldade em registrar o que pessoas falam ao mesmo tempo. No caso do estenotipista, apesar de o profissional ser treinado para transcrever as frases corretamente, erros também podem ocorrer, dada a alta velocidade de digitação.
Mas só isso não explica tudo, diz Leonardo Coelho David, fundador da Closed Caption Brasil. “Isso ocorre porque no Brasil não há uma preocupação como nos Estados Unidos em produzir legendas de qualidade. As emissoras deveriam contratar especialistas no assunto e melhorar o padrão de qualidade. Não se respeita o direito das pessoas portadoras de deficiência auditiva”, reclama.
Como a legenda vai parar na televisão?
A imagem que vemos na televisão é composta por um grande número de linhas verticais e horizontais (um aparelho de alta definição, por exemplo, apresenta 1080 linhas). Na chamada “linha 21” é feita uma espécie de interrupção do sinal para a próxima linha (o termo técnico é “intervalo de apagamento vertical"), onde são inseridos os dados das legendas, que não aparecem de imediato na imagem, daí o nome “legenda oculta”. A informação fica contida no sinal enviado à TV até sua casa, basta acionar o botão do controle remoto (também existem aparelhos decodificadores de closed caption, menos comuns) para visualizá-las.
Como surgiu?
A ideia de criar as legendas ocultas surgiu há cerca de trinta anos, nos Estados Unidos, explica David. “Naquela época, a intenção era auxiliar pessoas com deficiência auditiva a acompanharem os programas. Em 1976, a Comissão Federal de Comunicações regulamentou as transmissões com closed caption, que passaram a ser usadas em programas gravados. As legendas ocultas só chegariam a programas ao vivo em 1982, na transmissão da Cerimônia do Oscar.
Como veio parar no Brasil?
David conta que, no início dos anos 90, tentou oferecer a tecnologia de captura de legendas para uma grande emissora no Brasil, mas não houve interesse. Foi a partir de 1997 que o uso de legendas ocultas começou a crescer nas emissoras: naquele ano, o Jornal Nacional, da Rede Globo, passou a usar o recurso.
O closed caption é obrigatório no Brasil?
Ainda não. Em 2000, o senador Lúcio Alcântara (PSDB-CE) propôs um projeto de lei para obrigar emissoras de TV a incluírem as legendas ocultas na programação. O projeto seguiu para a Câmara dos Deputados, foi incluído em outras propostas de acessibilidade e, desde então, continua em tramitação junto ao PL 2.462, do deputado Ricardo Izar (PSD). Esse último projeto pede um cronograma de adoção de percentuais mínimos de programas com closed caption.
As legendas servem apenas para deficientes auditivos?
Não, além das pessoas que possuem algum tipo de deficiência auditiva (no Brasil, eles são 9,8 milhões, segundo dados do IBGE-2010), as legendas ocultas também ajudam, diz David, idosos, que sofrem a perda natural da capacidade auditiva com o avançar da idade; crianças em alfabetização; analfabetos em processo de aprendizado da língua.
Além dessas pessoas, já é comum encontrar televisores em locais públicos e barulhentos com o recurso ligado, como bares, restaurantes, salas de espera etc.
Todas as TVs têm o recurso Closed Caption?
Atualmente, sim. Para terem a habilidade de mostrar as legendas, os televisores necessitam de um circuito eletrônico especial, que nos Estados Unidos desde os anos 90 é inserido nos aparelhos. Essa tecnologia acabou sendo repassada às fábricas no mundo.
Como as emissoras de televisão contratam esse serviço?
Segundo David, existem várias empresas no Brasil que oferecem o serviço de closed caption e, normalmente, essas companhias são ligadas a emissoras de TV e produtoras de vídeos.
terça-feira, 24 de abril de 2012
Investidores chineses buscam investir em fornecedores da Apple
Por Samuel Shen e Kazunori Takada
XANGAI, 24 Abr (Reuters) - As rígidas regras de capital da China proíbem que os cidadãos do país invistam diretamente na Apple, mas isso não os impede de buscar uma participação no sucesso da fabricante do iPhone por meio da compra de ações de seus fornecedores -e mesmo de empresas as quais apenas boatos as indicam entre os fornecedores.
Há uma corrida de investidores para adquirir ações das duas únicas empresas chinesas de capital aberto que a Apple confirmou como fornecedores, causando alta considerável em seu valor de mercado, e a especulação é forte quanto a ações de companhias que o mercado acredita estarem indiretamente envolvidas com a gigante da tecnologia.
A Suzhou Anjie Technology teve alta de mais de 30 por cento em suas ações, e a BYD, uma montadora de automóveis na qual o investidor norte-americano Warren Buffett tem participação, saltou em mais de 15 por cento desde a metade de janeiro, quando os nomes de ambas fora mencionados na primeira lista de fornecedores publicada pela Apple. O Índice Composto de Xangai subiu em 5,6 por cento no mesmo período.
"Os investidores querem participar do crescimento da Apple porque acreditam que as vendas do iPad e do iPhone continuarão fortes", disse Zhou Feng, analista da Donghai Securities.
"Investir nos fornecedores da Apple não é uma má ideia, porque eles são como as garotas que saem com o cara rico", acrescentou.
As ações da Apple, listadas na Nasdaq, atingiram o recorde de 644 dólares neste mês. Depois, caíram em 11 por cento, fechando em 571,70 dólares na segunda-feira. Ainda assim, acumulam 41 por cento de alta em 2012.
O mais perto que um investidor individual chinês pode chegar de deter ações na Apple, dada a proibição à aquisição de ações estrangeiras, é a compra de cotas em um dos fundos de investimento internacionais autorizados sob o programa de Investidor Institucional Interno Qualificado. Alguns desses fundos investiram em ações da Apple.
O programa é o principal canal para que as pessoas físicas chinesas invistam em mercados de capital estrangeiros.
Google lançará armazenamento de dados para consumidores
O Google está preparando o lançamento de um serviço para permitir que fotos e outros conteúdos online possam ser armazenados online por internautas, afirmou uma fonte próxima do assunto. A iniciativa baterá de frente com um mercado dominado atualmente por empresas como Dropbox e Box.
O serviço, que se chamará Google Drive, poderá ser anunciado ainda nesta terça-feira e será oferecido em versões gratuitas e pagas, informou a fonte.
A oferta do Google vai incorporar recursos de busca e permitirá aos usuários guardar fotos, textos e outros documentos na Internet e acessar esse conteúdo por qualquer dispositivo com conexão à Web.
Os consumidores terão 5 gigabytes de espaço gratuito no Google Drive, enquanto outras versões vendidas sob pagamento mensal terão vários tamanhos, chegando a 100 gigabytes, acrescentou a fonte.
Não ficou imediatamente claro quanto o Google vai cobrar pelas versões premium do serviço. Uma porta-voz do Google afirmou que a companhia não comenta rumores.
O Google gera 96 por cento de suas receitas com venda de publicidade. A empresa faturou 38 bilhões de dólares em 2011.Uol Tecnologia.
Atualização do Dropbox facilita compartilhamento de arquivos
Por Glenn Fleishman, Macworld / EUA 23-04-2012
O serviço de sincronização de arquivos hospedados na rede Dropbox atualizou nesta segunda-feira, 23/4, seus aplicativos desktop, mobile e web para permitir que qualquer arquivo ou pasta armazenados em um diretório de sincronização de usuário seja compartilhado com outras pessoas por meio de um link acessível pela Internet.
Os arquivos e pastas compartilhados fazem uso do sistema de preview baseado na web que permite que imagens, vídeos, e documentos sejam visualizados, ouvidos, ou lidos sem a necessidade de um app externo, além de também serem simplesmente baixados.
Essa é uma mudança significativa para o Dropbox, que é focado quase que inteiramente no acesso baseado em contas tanto para sincronização individual quanto para colaboração usando pastas compartilhadas. A novidade torna muito mais fácil a visualização e o download de arquivos armazenados com o Dropbox para quem não possui conta no serviço. Isso coloca o Dropbox em concorrência com sites especializados na transferência de arquivos, como Pando, TransferBigFiles, e YouSendIt.
Anteriormente, o Dropbox já havia permitido o compartilhamento público de arquivos (mas não pastas) que estavam colocados na pasta Pública (Public) em seu diretório padrão. Os usuários podiam então clicar para controlar um arquivo e, a partir do menu do Dropbox, selecionar a opção Copiar Link Público (Copy Public Link). Exigir o uso de uma pasta especial significava que a maioria dos usuários não sabiam que o recurso existia, afirmou um representante da companhia. Visualizar o link público também causava comportamento inconsistente, uma vez que, dependendo do tipo do arquivo, alguns navegadores tentariam carregar e exibir os arquivos inteiros (como com um arquivo de áudio ou vídeo), falhar na tentativa de download ou baixar o arquivo imediatamente.
A nova opção torna o compartilhamento contextualmente disponível para qualquer arquivo (sob a marcação Get Link) armazenado em qualquer lugar no diretório de sincronização, e também estende o compartilhamento para pastas. As versões móvel e web do Dropbox também foram atualizadas para permitir o compartilhamento de qualquer item ao se clicar ou tocar em um ícone com link ligado. Arquivos e pastas compartilhados são visíveis ao se abrir a URL em um navegador, mas itens podem ser baixados ou, com uma conta paga ou gratuita, copiados para o diretório Dropbox do visualizador. Links compartilhados também podem ser desabilitados a qualquer momento, o que também é um novo recurso. (O novo aspecto de compartilhamento do serviço lembra o CloudApp, um serviço de compartilhamento na nuvem de arrastar e largar.)
O cofundador do Dropbox, Drew Houston, afirmou que a intenção da companhia era tornar mais óbvio para os usuários que os arquivos podem ser compartilhados publicamente enquanto estende a funcionalidade para pessoas que não possuem contas no serviço. “Nós queríamos que essa fosse uma experiência realmente simples”, disse. “Você pode compartilhar arquivos enormes e não apenas arquivos individuais, mas coleções inteiras de documentos”, uma nova capacidade pela qual os usuários pediram, informa o executivo.
Dúvida do leitor: o que é importante observar ao comprar um netbook?
Flávio Carneiro Do UOL, Em São Paulo
O leitor Edgar escreveu ao UOL Tecnologia perguntando qual é a melhor opção de netbook do mercado. O usuário gostaria de comprar o portátil, mas não sabe o que deve observar antes de realizar a aquisição.
Se tiver alguma dúvida sobre tecnologia, envie um e-mail para uoltecnologia@uol.com.br, que também ela pode ser respondida.
Antes mesmo de avaliar as opções de compra, é preciso definir para que a máquina será utilizada. Um computador apenas para leitura de e-mail e navegação na internet não precisa de mais que 1 GB de memória RAM. Já para quem deseja assistir a filmes (mesmo com a tela pequena), o ideal é que o equipamento possua, ao menos, 2 GB de RAM.
O fato de o netbook, normalmente, não possuir drive de CD ou de DVD, faz com que a requisição de portas USB aumente. Por isso, quanto mais entradas, melhor (no mínimo 3 são indicadas). Para quem deseja utilizar a internet, é importante ficar de olho se o aparelho inclui placa wireless para captar rede sem fio.
Usuários que desejem reproduzir o conteúdo do eletrônico na TV devem escolher um produto com entradas HDMI. Esse sistema facilita a transmissão de informações para o televisor (TVs mais modernas já possuem esse tipo de entrada, na qual um único cabo diretamente conectado a ambos os aparelhos transfere imagem de alta definição e áudio ao mesmo tempo, dispensando outros fios).
Por fim, deve-se prestar atenção no sistema operacional que acompanha a máquina. Boa parte dos netbooks é vendida com distribuições Linux, um sistema operacional livre, bastante rápido e versátil (e que também torna o preço da máquina mais em conta). Há também, no mercado, opções com Windows XP ou 7, que normalmente exigem mais hardware e podem sair mais caras, já que esse tipo de sistema operacional é pago.
Uma empresa sem investimento em marketing sobrevive?
por Alessandro Azevedo (Webinsider]
Quem conhece uma empresa que não investe em marketing, levanta a mão aí!
Quando quase todos pensam que todo mundo está online, a gente que lida diariamente com o mercado percebe: não é verdadeira esta afirmativa. É claro, muitas empresas, organizações e instituições estão mesmo na web; têm site, têm ações digitais e não digitais, têm agência de publicidade, fazem e-mail marketing, têm vídeo institucional, etc.
Mas, – e porque sempre tem um “porém” em tudo – existem milhares de empresas que ainda não estão nem fazendo ações offline, muito menos online, ou seja, seguem tocando as suas vidas queiram ou não, sem nós, os profissionais de marketing.
Esta é uma realidade, é um fato, é o feijão com arroz de centenas de milhares de empresas espalhadas por aí. Todo mundo que trabalha na área conhece montes delas. A empresa tem uma estrutura razoável, está ativa nas Receitas Federal, Estadual, tem mais de 20 funcionários, vende, paga as contas, gera impostos para o estado, município, lucra e está aparentemente satisfeita com o seu dia a dia.
Já perguntei para alguns diretores, digamos assim, participantes deste nicho de mercado dos “sem marketing” e sabe o que eles respondem? – “ah, eu não preciso investir em propaganda porque além de gastar muito, não me dá resultado”. “Uma vez eu fiz isso e aquilo, gastei uma grana preta que poderia ser direcionada para compra de máquinas ou contratar mais funcionários e não vendi muito a mais que vendia antes”.
Tem outros que disseram: – “a minha esposa (filho/sobrinho/cunhado) cuida desta parte “do marketing” e eu não tenho tempo para cuidar de um site; meus concorrentes diretos nem tem site também, então, estamos empatados”.
E tem aqueles que são “iniciados no marketing”: – “eu participei de uma palestra sobre marketing e eu mesmo cuido disso, não preciso contratar nem agência, nem funcionários. E ninguém melhor do que eu para saber do que a minha empresa precisa, não é mesmo? E eu poderia listar aí pelo menos mais uns 30 casos ilustrativos e interessantes, mas não é o objetivo”.
Vamos provocar a seguinte reflexão: embora a internet, as redes sociais, smartphones, tablets, estejam aí para quem quiser, de graça, 0800, free, ou não, paga e com ótimas ferramentas, ótimos profissionais, etc., tem um universo de empresas ainda analógicas, offline, que pensam e agem como se estivessem muito bem, obrigado! E vamos além: como tirá-las dessa “zona de conforto”, como mostrar que, se elas investirem um pouco em marketing, do jeito certo, com planejamento, com profissionais focados, elas obterão um resultado positivo, ou seja, vão lucrar mais?
Esse é o mercado hoje, minha gente! Mesmo que existam os trocentos exemplos e cases de sucesso na mídia online, a vida também é feita de empresas que ainda não investem nem em marketing offline, nem online. Ponto. Fato.
As oportunidades dependem de uma visão ampla
Está aí uma oportunidade, um campo pronto para semear e colher. Quem entende um pouco de venda, ou que já assistiu alguma palestra sobre “como se tornar um vendedor em 10 lições”, ou quem já leu um, dois, ou 50 livros sobre vendas, sabe: sempre que um cliente diz NÃO, o bom vendedor tentará demovê-lo. O vendedor de primeira viagem vai abandonar o barco quando ouvir: “eu não preciso de site porque eu vendo até domingo com chuva, comendo bolinhos”…
No dia 28 de fevereiro de 2012 foi publicada esta notícia que repercutiu nos principais jornais e portais de internet do país: o consumo no Brasil deverá atingir o total de R$ 1,3 trilhão em 2012, segundo previsão do Ibope Inteligência por meio da ferramenta de pesquisa Pyxis Consumo. O índice aponta um crescimento de 13,5% em comparação a 2011 e o valor deve ser equivalente a 30% do Produto Interno Bruto brasileiro (PIB).
Estes números refletem e são consequência do bom momento econômico pelo qual passa o nosso país, o nosso Real valorizado, aliado ao ótimo índice de empregabilidade do trabalhador, aumento do poder de compra da chamada classe C, responsável por mais de 53% do consumo, acompanhada aí pelas classes D e E que também estão abarcando uma parcela expressiva de compra.
Pergunto: quem quer fazer parte deste mercado? Certo que todo mundo responderá SIM. É aí que mora o perigo, como se diz, porque todo mundo quer vender, quer lucrar, quer crescer, quer girar na roda da economia. E isso tem um preço, meus amigos! O concorrente que vende a mesma coisa que a sua empresa produz está aí, correndo por fora, imaginando e fazendo coisas para se diferenciar de você.
A China faz tudo e o que ela não faz, fará. A concorrência pode e usa o marketing ao seu favor porque ele funciona. Fato.
Então, meus amigos, vou elencar a seguir oito dicas para você se cercar de bons profissionais e fazer o marketing da sua empresa bombar, participando da roda da economia mundial.
Primeira dica. Aceite que você não é obrigado a contratar ninguém, mas também aceite: assim como chamou um contador, um administrador, um gerente, um advogado, um engenheiro, um operador de torno CNC, contratou uma boa empresa de segurança, de limpeza, você deve, sim, chamar um profissional de marketing. Pode ser uma agência de propaganda ou pode ser um marketeiro de alma, experiente como todos os outros excelentes funcionários que trabalham para você.
Segunda dica. Desconfie sempre do pilha-fraca. Explico: é aquele que vem lhe atender com síndrome do miojo (joga água quente e come), já vem com tudo pronto na cabeça, cheio de marketês complicados e que você nunca ouviu e, se ouviu, não sabe para que serve; às vezes, nem o pilha-fraca sabe. Escolha aquele que, além de você poder bancá-lo, queira fazer acontecer, com vontade, com ideias boas de verdade, mas factíveis.
Dica 3. Não se preocupe tanto com o custo. Tudo tem um preço na vida. Mas negocie porque a concorrência no marketing é monstruosa, acerte uma forma adequada de pagamento dos honorários do profissional que tanto pode ser mensal quanto por demanda.
Dica 4. Envolva-se o quanto puder no processo de troca de informações da sua empresa, mercado, produto, serviço, ao profissional de marketing; quanto mais informações melhor o plano de marketing, melhores ideias e, consequentemente, melhores resultados. Cobre resultados, mas volto a dizer: não existe mágica! Fazer aquelas ações a granel para daqui a 15 dias ou um mês querer colher não existe mesmo. Investe um pouco, colhe um pouco; investe mais, colhe mais. Se a ideia for ruim e mal executada, nem inserção no Jornal Nacional garante resultado, mas vai lhe custar milhões de reais!
Dica 5. O que funciona para uma empresa não é receita de bolo e talvez não seja o ideal para a sua. Nem tanto ao céu, nem tanto à terra. Não há receita para fazer só ações offline ou online, talvez o ideal seja trabalhar sempre com ambas, conforme o seu orçamento, conforme o plano estabelecido, conforme o prazo; confie no profissional. Têm profissionais que ficam seduzidos por uma ferramenta ou ideia e tentam de todas as formas provar que ela é a única bola da vez. Não é verdade. O cartão de visita da sua empresa tem que ser o melhor possível e o e-commerce também! O folheto funciona e a propaganda na TV também! Panfleto é bom e e-mail marketing também.
Dica 6. Inspire o profissional de marketing para que ele vista a camisa da empresa e cresça junto com ela, afinal de contas, falamos de fidelizar clientes e você é o cliente dele.
Dica 7. Faça os seus funcionários participarem do processo desta nova cultura de marketing da empresa. Apesar de você, às vezes, pensar o contrário, os funcionários conhecem muito bem a sua empresa, de um ângulo que nem você conhece. Ninguém quer trabalhar em um lugar onde não há chance de crescer; está bem, tem aquele que só quer fazer o feijão com arroz, bater ponto, receber e se aposentar. É o tipo de funcionário pilha-fraca também. Mas tem o que veste a camisa, tem ideias! Seja parceiro desses funcionários, junte-os com o profissional do marketing e depois premie as melhores ideias e que renderam mais resultados. Um incentivozinho é sempre bem-vindo, não é mesmo? Todo ser humano gosta!
A última dica. Aplique sempre na sua empresa os 10 P´s do Marketing – até o 4º P é obra do marqueteiro McCarthy, os outros são meus.
Produto;
Preço;
Promoção;
Ponto de venda;
Pense muito (assim que surgem as ideias);
Profissionalize-se (delegue para quem pode fazer mais e melhor);
Produza mais e melhor (se produzir mais, terá que vender mais);
Projete o futuro (o aqui e o agora passam rápido);
Pense mais (tem muita gente que depende disso);
Ponha em prática (se não der para por em prática, esquece, parte para outra).
MSI anuncia dois novos notebooks para games, o GT70 e o GT60
Adrenaline - autor: jose
A MSI anunciou dois novos modelos de notebooks para games, o GT70 e o GT60, equipados com Chipset Intel HM77 e processador Core i7 geração Ivy Bridge anunciada ontem, GPU GeForce GTX 670M da Nvidia, Game Networking E2200 da Killer e teclado luminoso Steel Series.
O modelo GT70 vem com tela Full HD anti-reflexo de 17,3 polegadas que promete maximizar a experiência visual em todas as condições de luminosidade, teclado full color com 1000 combinações de cores customizáveis, conexões de áudio amplificadas para sons mais nítidos e 12 GB de memória DDR3. Para gamers que estiverem procurando mais energia, o GT70 também está disponível com 16 GB de DDR3, BD Burner e configuração Super RAID 0 da MSI.
Com potência semelhante, o GT60 de 15,6 polegadas também vem equipado com tela Full HD anti-reflexo e uma série de componentes, incluindo dois HDs em RAID 0 para um espaço de armazenamento de 1TB e 12 GB de memória DDR3.
“Equipados com a mais nova GPU da Nvidia, com o Chipset Intel e com o Game Networking da Killer, o GT70 e o GT60 redefinem a jogabilidade móvel e proporcionam performance superior que excede até mesmo as expectativas dos gamers mais exigentes”, disse o vice-presidente de vendas da MSI nos EUA, Andy Tung.
Ambos os modelos vêm com dois anos de garantia de fábrica e serão vendidos a partir de US$ 1.499,99.
segunda-feira, 23 de abril de 2012
Microsoft aposta em tablets acessíveis para frear Apple
Diminuir a participação da Apple no mercado mundial de tablets para menos de 50% até 2013. Essa é uma das principais metas da Microsoft, que espera ter nos EUA apenas esse ano cerca de 32 desses dispositivos com preços médios de US$ 300, rodando o sistema operacional WindowsRT, versão do Windows 8 para tablets.
Nessa “briga” com a Apple, a Microsoft contaria com a ajuda de fabricantes como HP, Dell, Lenovo, Acer, Asus e Toshiba, que utilizariam o sistema operacional da empresa em parte de seus novos tablets.
Obviamente o preço baixo tem como foco não apenas o iPad e sua legião de fãs, mas também os gadgets que rodam o sistema operacional Android. Para chacoalhar esse mercado, a Microsoft e os fabricantes que adotarem o Windows RT apostam no preço acessível, menos de US$ 300, como grande atrativo para conquistar novos usuários.
Atualmente, a Apple tem mais de 70% do mercado mundial de tablets, graças as três versões do iPad.
Fonte: Slashgear Posted by Eduardo Bonjoch on Abril 23, 2012. Planet Tech.
Processadores Ivy Bridge da Intel aguardam a chegada do Windows 8
Os primeiros processadores com arquitetura Ivy Bridge, da Intel, devem ser lançados nesta segunda-feira (23/04), de acordo com a Cnet. Assim como o Olhar Digital já havia divulgado no início do mês, os novos chips da empresa prometem melhor desempenho em gráficos e reprodução multimídia e será a primeira linha da companhia a usar transistores 3D, e a ter suporte a USB 3.0.
Ainda não foram anunciadas máquinas que usem os novos processadores, mas, de acordo com rumores, a próxima geração de MacBooks contará com os processadores Ivy Bridge. Além disso, segundo a publicação, o maior alvo da companhia é o Windows 8, sistema operacional da Microsoft que irá substituir o Windows 7.
“Com o Windows 8 teremos um sistema operacional dominante que irá incorporar a tela touchscreen”, comentou Paul Otellini, CEO da Intel. “Nossa visão é que, nos novos modelos de ultrabooks, o touch será uma exigência. Quando os usuários verem a nova interface do Windows 8, eles vão querem tocá-la. Se a tela não tiver esta opção, os consumidores vão ficar desapontados”, finalizou.
Provavelmente, os consumidores também verão a nova família da Intel em Ultrabooks populares como HP Folio e Dell XPS. Portanto, até a chegada do Windows 8, os usuários terão de se contentar com o velho Windows 7, ainda bastante querido por muitos.
Por conta disso, segundo o Cnet, o anúncio desta segunda-feira deverá se focar, ainda, nos computadores com Windows 7. Os primeiros processadores serão para desktops e notebooks quad-core e, a partir de maio ou junho, será possível ver os chips dual-core para laptops convencionais e Ultrabooks mais modernos. Olhar Digital.
G55VW-DS71, notebook para games da ASUS, já tem preços divulgados
A série G de notebooks da ASUS já esquenta o colo dos gamers há algum tempo, seja o G74 ou o G73JH. A mais nova na família agora é a linha G55, que estreia no mercado com o G55VW-DS71, que teve suas especificações divulgadas no mercado na última semana.
Ele terá um processador quad-core i7-3610QM Ivy Bridge funcionando em conjunto com o GTX 660M de 2GB da Nvidia para cuidar dos gráficos. Ele terá um DDR3 de 12GB a 1.333 MHz de RAM, além de um HD de 750 GB.
Também há duas baias de drives que podem ser customizadas ao gosto do cliente. Novas versões dessa máquina de 15,6 polegadas estão para vir no futuro, mas a G55VW-DS71 está disponível apenas para pré-venda, no momento. Uol Tecnologia
Consumerização e o impacto no design
Por Computerworld - Computerworld é uma propriedade da International Data Group, Inc., licenciado pela Now!Digital Business Ltda.
Por Paul D’Arcy *
Em um mundo cada vez mais demandante, a separação entre o ambiente de trabalho e a casa está desaparecendo, e a tecnologia tornando-se parte integrante do modo como vivemos nossas vidas. Novos dispositivos móveis, mais avançados e repletos de recursos e aplicativos são lançados a cada dia. Ao mesmo tempo, o trabalho móvel continua a aumentar.
A enorme variedade e o alto nível de funcionalidades à disposição do consumidor moderno mudaram significativamente as expectativas que os profissionais têm de sua tecnologia corporativa. Na verdade, o Gartner prevê que a consumerização é a tendência que vai ter o maior impacto sobre a empresa de TI na próxima década; desafiando CIOs e departamentos de TI a balancear os desejos do funcionário com as necessidades de negócio.¹
A nova classe de negócios
O profissional da Geração Y é motivado pela carreira, enquanto mantém forte autoidentidade e senso de estilo pessoal. A mudança na forma como os profissionais usam e percebem a tecnologia, juntamente com a consumerização de TI, tem propiciado o surgimento de um novo profissional de negócios – aquele que considera que o dispositivo escolhido deve realizar as tarefas de forma mais otimizada e, além disso, ser seu reflexo no trabalho ou em casa.
Na medida em que as demandas de funcionários evoluem, a TI corporativa é desafiada a gerenciar e suportar um número cada vez maior de dispositivos, além de capacitar os funcionários com as ferramentas que precisam para trabalhar de forma mais eficiente e segura, onde quer que estejam.
Expectativas do usuário final estão concentradas na escolha
No fim das contas, os usuários finais querem possibilidade de escolha e flexibilidade, que devem ser disponibilizadas pelos empregadores e pelos departamentos de TI. Para eles, os fatores mais importantes na escolha de tecnologias corporativas são estilo, conforto e desempenho.
Estilo: a imagem que retrata clientes e colegas é cada vez mais importante para os profissionais da Geração Y – maletas pretas e ternos cinza não são mais a norma em um mundo onde a criatividade e a individualidade são muito elogiadas.
Os trabalhadores antenados esperam escolher entre uma gama de fatores que medem características como design, elegância e estilo de modelos similares aos voltados para consumidores finais, assim como a funcionalidade do produto. Os trabalhadores querem que o dispositivo corporativo seja uma expressão deles mesmos, destacando a necessidade de dispositivos corporativos refletirem o estilo pessoal.
Além disso, os profissionais de hoje já não consideram seu laptop uma ferramenta, mas sim uma extensão de si e parte de como eles se comunicam e colaboram com colegas ao redor do mundo. Design é fundamental – acabamentos superiores, materiais autênticos e refinados são essenciais para garantir apelo ao consumidor.
Comforto: a adoção do trabalho móvel não mostra sinais de diminuir, e a previsão é de Europa Ocidental ter aproximadamente 129,5 milhões de trabalhadores móveis em 2013, cerca de 50% da força total de trabalho². Dispositivos grandes e pesados que podem ser facilmente danificados não favorecem essa maneira nova e flexível de trabalho e, é claro, eles não retratam a imagem elegante que esperam os profissionais.
Além disso, os profissionais não apenas esperam, mas estão começando a exigir produtos com apelo ao consumidor e ergonomia de negócios, como teclado, track pad e point stick com ISO. Garantir que esses recursos estejam disponíveis permite aos profissionais realizar o trabalho onde quer que estejam, com conforto e estilo.
Desempenho: como o escritório pode estar onde quer que seja, os profissionais modernos são particularmente exigentes. Os dispositivos precisam ser duráveis e resistentes, com linhas arrojadas e limpas e que oferecem conectividade excepcional, desempenho e confiabilidade. Para permitir que os trabalhadores acessem dados corporativos de maneira segura onde quer que estejam, a segurança precisa ser um pilar fundamental no processo de design. Os produtos corporativos devem ser capazes de oferecer acesso seguro e proteção de dados agrupados em um dispositivo com apelo ao consumidor, mas sem sacrificar o desempenho.
Necessidades de negócio e requisitos de design
Com esse nível de escolha para os usuários finais, surgem alguns desafios para TI. Enquanto o número de dispositivos gerenciados pela organização de TI continua a crescer, o mesmo acontece com o tempo e os recursos necessários para gerenciar e manter esses dispositivos. Em muitos casos, os desafios práticos da gestão de uma crescente variedade de dispositivos, sistemas operacionais e configurações estão levando o departamento de TI a resistir ao uso de dispositivos alternativos. No entanto, por volta de 2013/14, esses departamentos de TI corporativos que não permitirem opções diversificadas de dispositivos e as escolhas do usuário final por meio de ênfase no gerenciamento, execução de políticas e avaliações de segurança, se tornarão irremediavelmente fora de moda e lutarão para funcionar³, o que irá causar o caos e aumentar substancialmente o Custo Total de Propriedade da organização.
Na era da consumerização, o design da computação empresarial deve endereçar alguns requisitos fundamentais, tais como:
•Capacidades de plataforma comuns eliminam o problema de gerir uma multiplicidade de dispositivos. A gestão centralizada é possível com uma ferramenta e uma imagem comum, reduzindo drasticamente o tempo e os recursos necessários para implantar e gerenciar dispositivos da força de trabalho; permitindo-lhe fornecer a funcionalidade de uma forma muito mais eficiente e rentável.
•Virtualização de Desktop está rapidamente se tornando o principal caminho para energizar a força de trabalho da próxima geração, que é cada vez mais móvel e espera ser capaz de trabalhar a partir de onde estiver de uma maneira produtiva, segura e livre de problemas. Soluções thin client oferecem conectividade e flexibilidade para os funcionários, enquanto mantêm-se seguras e gerenciáveis para a equipe TI. Melhor ainda, os dispositivos devem ser concebidos com tecnologias embutidas como virtualização de desktops para ajudar no gerenciamento do dispositivo em um mundo cada vez mais heterogêneo.
•Segurança é mais importante do que nunca. Com o custo médio de uma violação de dados em 4 milhões de dólares4, a necessidade de uma solução integrada e abrangente de proteção de dados é clara. Com o número de dispositivos continuamente crescendo e evoluindo, os CIOs precisam garantir que a solução de segurança escolhida seja capaz de abarcar a multiplicidade de dispositivos – e que os dispositivos sejam projetados com a segurança em mente. Por exemplo, criptografia integrada às fábricas pode oferecer uma solução flexível, gerenciável e auditável, permitindo que as organizações protejam dados em laptops e desktops, bem como mídia externa.
Balanceando os desejos do profissional com as necessidades de negócios
A consumerização de TI está claramente liderando uma mudança nas expectativas profissionais e no que TI deve fazer para cumprir esses requisitos. Um estudo recente da Unisys indicou que uma grande porcentagem de funcionários classificou as ferramentas de tecnologia como um fator crítico na escolha de um empregador e, por sua vez, o modo como os fornecedores abordam o design de produtos comerciais. Para os CIOs e profissionais de TI, encontrar um design que equilibre a escolha do funcionário e as expectativas, e as soluções práticas para a gestão desses dispositivos pode ser desafiador. Fornecedores com pensamento inovador estão respondendo, ao manter em mente o ambiente de trabalho moderno e ao desenvolver produtos comerciais de computação destinados a facilitar a produtividade, com gerenciamento simplificado e esteticamente agradáveis à força de trabalho.
(*) Paul D’Arcy é diretor de Marketing da Dell para Large Enterprise nos EUA e para Public e Large Enterprise na América Latina e Canadá
¹ Gartner. (10 Fevereiro de 2010). Findings: In January 2010, the Consumerization of IT Became a Business Strategy Issue (G00174465). 16. Raskino, M.
²Mobile workers to top 1 billion worldwide thanks to VOIP, UC: IDC
³Jack Gold Associates, Technology Trends for 2011, Janeiro de 2011
42010 Global Study: Annual cost of Data Breach
iPad é mais amado do que PCs e smartphones, revela pesquisa
De acordo com levantamento da Viacom, usuários dizem que produtos como iPad fazem com que se sintam "mais felizes e relaxados"; maior parte do uso acontece em casa
Por Jeff Bertolucci, PC World / EUA 23-04-2012-
Um novo estudo da Viacom mostra que três quartos do uso de tablets acontece em casa, e que essa utilização é na maior parte das vezes uma atividade solitária. A pesquisa chamada de “Tapping Into Tabletomics” toma como base um levantamento online feito com mais de 2.500 pessoas com idade entre 8 e 54 anos, assim como entrevistas com usuários “dedicados” de tablets em Los Angeles e Nova York, diz a companhia.
A preferência pelo uso de tablets em casa pode explicar a razão pela qual a grande maioria dos donos desses aparelhos preferem produtos apenas com Wi-Fi em vez de versões com conexões celulares, que costumam ser mais caras.
Uma descoberta peculiar da pesquisa revela que os usuários de tablet possuem uma ligação emocional mais forte com seus produtos do que com outros aparelhos eletrônicos.
Mais de metade dos entrevistados afirmou que seus tablets fazem com que se sintam “mais felizes e relaxados”; 40% deles disseram que seus tablets “revelam o melhor em mim”.
“O iPad é minha forma de entretenimento, relaxamento, diversão e oportunidade para conseguir informações. É meu espaço pessoal, de certa maneira”, disse uma das entrevistadas sobre seus sentimentos pelo tablet.
PCs e smartphones não são tão amados pelos seus donos. Quase dois terços dos entrevistados disseram que substituiriam seus laptops pelos seus tablets, e mais de três quartos afirmaram que trocariam seu iPhone pelo iPad.
Confira abaixo outras descobertas interessantes do estudo da Viacom:
62% dos donos de tablets usam seus aparelhos diariamente
Os usuários diários passam cerca de 2,4 horas por dia com seus tablets
85% do uso de tablet é para atividades pessoais não-profissionais
A maioria das “atividades de mídias” em tablets, como jogar games e assistir TV, é mais comum entre usuário com idade entre 18 e 24 anos
Os tablets superaram os computadores como um “aparelho de segunda tela” para visualização de programas de TV
Samsung compara usuários de iPhone com ovelhas em novo anúncio
A Samsung liberou hoje, 23/4 outro comercial com provocações contra a rival Apple. O clipe faz parte da divulgação do seu evento Unpacked 2012, que acontece em Londres no próximo mês de maio e deve ser palco da apresentação do novo smartphone Galaxy S III.
Com um minuto de duração, o vídeo mostra imagens do espaço enquanto aparecem na tela frases como “Onde uma galáxia cabe perfeitamente na sua mão, sua visão do mundo pode ficar mais ampla do que nunca à medida que você ganha força para explorá-lo (mundo) de maneira livre e ágil”.
A provocação contra a rival e (parceira em algumas frentes) Apple fica para o final do vídeo, quando são mostradas imagens de ovelhas juntamente com os dizeres “Com tecnologia que se encaixa assim facilmente, você agora pode se destacar de todos os outros”.
Essa não é a primeira vez que a Samsung ataca os fãs da Apple em seus comerciais. A empresa lançou no ano passado uma campanha que fazia piada com usuários do iPhone que acampam em frente a lojas da Apple enquanto esperam o lançamento de um novo modelo do smartphone.
Apesar de a Samsung ser uma das principais fornecedoras da Apple, as duas empresas estão envolvidas em diversas batalhas judiciais envolvendo acusações de supostas violações patentes de seus aparelhos móveis.
Apesar de o Galaxy S III não aparecer no vídeo mais recente da Samsung para o evento Unpacked, o aparelho teria sido visto em vários vídeos que circulam na web atualmente. Na semana passada, um aparelho que suspeita-se ser o S III apareceu em um vídeo postado no site vietnamita Tinhte, famoso por revelar novos smartphones não-lançados.
Segundo estudo, Apple apresenta mais falhas de segurança que Google e Microsoft
Segundo uma pesquisa feita pela TrendMicro, usuários da Apple já não podem mais se orgulhar de utilizar um ambiente seguro. A empresa lidera a lista de vulnerabilidades entre as dez maiores do mercado, como Google e Microsoft.
De acordo com o relatório, nos primeiros três meses de 2012, a empresa registrou 91 vulnerabilidades, contra 78 da Oracle, 73 do Google, 43 da Microsoft, 42 da IBM, 36 da Cisco, 30 da Mozilla e 27 da Adobe.
O relatório da TrendMicro também revela que a Apple bateu recordes de vulnerabilidades em Março, quando lançou pacotes de correção para o Safari, navegador da companhia.
Um dos casos mais recentes – e, talvez, mais graves – foi o do malware Flashback, que imitava uma atualização do Flash Player e desativava softwares de segurança dos Macs de usuários. Esse vírus infectou cerca de 600 mil máquinas da Apple no mundo todo, número que só diminuiu após o lançamento de atualizações pela empresa.
Já no caso do mundo móvel, quem sai perdendo a disputa pela segurança é o Google. Seu sistema móvel, o Android, foi o que teve mais casos de aplicativos maliciosos registrados no período: 5 mil. Robert McArdle, pesquisador da TrendMicro, diz que "o ponto-chave é pensar antes de dar acesso aos seus dados para um app. Se você não quer expor informações privadas, simplesmente não o faça".
Governo pode diminuir impostos dos smartphones
POSTADO POR Paulo Floro , ÀS 16:59 EM 23/04/2012
Como o intuito de popularizar a banda larga no País, o governo decidiu apostar na disseminação dos smartphones, que são celulares que também permitem acesso a internet. Para isso, pretende tirar a cobrança de PIS e Cofins, atualmente de 9,25%, sobre os aparelhos desse tipo produzidos no Brasil. Em contrapartida à desoneração, os fabricantes terão de produzir celulares seguindo uma série de requisitos mínimos de tecnologia e esses telefones não poderão custar mais de R$ 900 para o consumidor final. As informações são da Agência Brasil.
As sugestões estão em documento do Ministério das Comunicações, ao qual o jornal “O Estado de S.Paulo” teve acesso. A proposta precisa do aval do Ministério da Fazenda. O ministro das Comunicações, Paulo Bernardo, disse na sexta-feira que espera o início do estímulo à produção local desse tipo de aparelho já no segundo semestre. Segundo ele, as tratativas iniciais na Fazenda mostraram-se positivas. Ele alegou que não haveria impactos na arrecadação, pois a produção de celulares no Brasil é baixa – no caso de smartphones, inexistente em grande escala.
Apenas levando-se em conta a desoneração de PIS e Cofins sobre a receita bruta de venda no varejo de smartphones produzidos no País, o impacto da desoneração é estimado em R$ 1,9 bilhão até 2015. Para conseguir a isenção, os smartphones terão que oferecer uma série de requisitos, como suporte à tecnologia 3G, conexão Wi-Fi, permissão a acesso de páginas no padrão HTML e também pré-configuração de contas de correio eletrônico e redes sociais, entre outros.
Na avaliação das Comunicações, o incentivo fiscal à produção doméstica de smartphones promove a indústria local e reduz a dependência externa.
segunda-feira, 16 de abril de 2012
Relógio inteligente da Sony acessa redes sociais, email e toca músicas
Postado por Paulo Floro , as 17:11 EM 13/04/2012
A Sony divulgou o seu novo relógio inteligente, o SmartWatch, o mais próximo que todos nós chegaremos dos filmes de James Bond e Dick Tracy. Com tela touchscreen de 1.3 polegadas OLED, ele acessa redes sociais e email. E vem com sistema operacional Android.
Com ajuda de um fone-de-ouvido bluetooth, ele consegue tocar músicas a partir de seu telefone Android, dando a praticidade de pular e retroceder faixas. Ele ainda acessa internet e possibilita acesso às redes sociais e também email.
O aparelho parece mesmo bonito, mas resta saber se o mercado vai perceber a necessidade de um produto tão específico. Para os fashionistas, além do apelo do design, ele conta ainda com mais de 20 combinações de cores.
O relógio inteligente será lançado este mês e custa 150 dólares. [Via Wired, Sony]
Microsoft estuda integrar Skype aos navegadores
De acordo com algumas ofertas de vagas de emprego que foram publicadas no site da Microsoft, tudo leva a crer que a empresa irá desenvolver uma versão do Skype para navegadores de internet.
As posições que foram descritas como "vagas para engenheiros de softwares" e afirmam que um aplicativo web do Skype seria criado com base no HTML5 e JavaScript e não usando o Silverlight ou Adobe Flash da Microsoft.
"A equipe Skype está à procura de engenheiros motivados e dedicados que queiram ajudar a levar a experiência do Skype para a Web", diz a oferta de emprego.
A criação de um aplicativo web que não requer o uso de plug-ins poderá proporcionar uma experiencia melhor do que o atual app do Skype para Facebook , e também permitir que qualquer pessoa com um navegador moderno possa usar o serviço sem ter que instalar o software.
As informações são do TechCrunch. Redação Adnews
McAfee Internet Security 2012: Proteção desigual e baixo desempenho
Nick Mediati, PCWorld EUA
O McAfee Internet Security 2012 (R$ 95,20 por uma licença válida por um ano, para até três PCs) foi o último colocado em nosso comparativo 2012 de 14 pacotes de segurança. Apesar da classificação ele se saiu bem em algumas áreas, mas o comportamento inconsistente que causou sua ruína em meio a um grupo extremamente competitivo de softwares.
Primeiro as boas notícias: o pacote da McAfee se sai muito bem na hora de detectar malware antes que ele infecte seu PC. Ele bloqueou 96.2% de todas as amostras de malware desconhecido em nossos testes no muindo real, um resultado um pouco acima da média em comparação aos outros pacotes que analisamos neste ano. E a detecção de 99.9% das amostras de malware conhecido foi o segundo melhor resultado que vimos neste ano. A marca de três falsos positivos (em uma amostra de 250 mil arquivos) não é a melhor que já vimos (muitos pacotes chegaram a zero), mas ainda assim é muito boa.
Mas embora o pacote da McAfee tenha mostrado um bom resultado nestes testes, a coisa muda de figura depois que o malware se instala em seu PC. O Internet Security 2012 detectou 80% das infecções ativas em nossa máquina de testes, um resultado abaixo da média. Apenas um outro pacote em nosso comparativo foi incapaz de detectar todas as infecções.
Além disso, o produto só conseguiu neutralizar as infecções em 70% dos casos, o segundo pior resultado neste teste. Em comparação, 9 dos 14 pacotes de segurança que testamos conseguiram desabilitar todas as infecções em nossa máquina de testes. Dito isto, o pacote da McAfee conseguiu eliminar todos os trações de uma infecção em 60% dos casos, um resultado ligeiramente acima da média.
O Internet Security 2012 também sofreu em nossos testes de desempenho, produzindo um impacto acima do normal no funcionamento de nosso PC. No teste de instalação de aplicativos ele adicionou 1,5 minutos ao tempo necessário para completar a tarefa (o segundo pior resultado), e na cópia de arquivos através da rede adicionou 2 minutos ao tempo, suficiente para garantir apenas o oitavo lugar.
A velocidade de varredura também não foi muito boa. A varredura sob demanda, iniciada manualmente pelo usuário, levou 1 minuto e 51 segundos para analisar um conjunto de 4.5 GB de arquivos, o décimo melhor resultado nessa categoria. Já a varredura no acesso, que é feita sempre que um arquivo é aberto ou salvo, desapontou muito mais: foram necessários 7 minutos e 4 segundos para completar a tarefa, novamente o segundo pior resultado entre todos os produtos analisados.
Gostamos da interface do McAfee Internet Security 2012. O instalador tem alguns toques inteligentes, como uma análise de seu PC e download da versão mais recente do software antes da instalação. Esta busca por uma atualização pode demorar um pouco em uma conexão lenta à internet, mas ainda assim é uma novidade bem-vinda. No geral o painel de controle principal do Internet Security é fácil de usar: amigável, limpo e bem organizado.
Por outro lado, o fato de que o Firewall pede que você decida manualmente quais aplicativos podem (ou não) acessar a internet não é nada amigável, e me parece um resquício de uma época onde era normal um pacote de segurança ser difícil e incômodo de usar.
Você deve comprar o McAfee Internet Security 2012? Embora ele não tenha se saído especialmente mal, e ofereça algumas coisas das quais gostamos, achamos muito difícil recomendar este pacote considerando sua posição no ranking. Se a McAfee conseguir aparar algumas arestas, pode valer uma olhada no futuro.
Samsung irá mostrar "o próximo Galaxy" em 3 de Maio
Mikael Ricknäs, IDG News Service Computerworld
A Samsung Electronics deverá mostrar seu próximo “super smartphone” da família Galaxy durante um evento em Londres no dia 3 de Maio. A empresa enviou à imprensa convites que dizem “venha e conheça o próximo Galaxy”. Mas quase não há dúvidas de que o aparelho apresentado será o sucessor do Galaxy S II, que foi lançado cerca de um ano atrás.
“A Samsung decidiu não lançar o Galaxy S III durante o Mobile World Congress em Fevereiro, então provavelmente será ele o produto mostrado agora”, disse Francisco Jeronimo, gerente de pesquisas do IDC.
O design do aparelho e suas especificações de hardware ainda não desconhecidos, mas os vários aparelhos mostrados durante o Mobile World Congress dão algumas dicas. Novatos como o HTC One X, já à venda no exterior, o LG Optimus 4X HD e o Huawei Ascend D tem processadores quad-core e telas com resolução de 1280 x 720 pixels.
Os modelos da HTC e LG tem telas de 4.7 polegadas, enquanto o da Huawei tem uma tela de 4.65 polegadas. Segundo rumores as especificações técnicas do Galaxy S III seguem essa linha, com uma tela de 4.6 polegadas e resolução de 1280 x 720 pixels que, segundo Jeronimo, deverá ser ainda mais brilhante que a do Galaxy S II. O aparelho também deverá incluir um processador quad-core desenvolvido pela Samsung e capacidade de conexão a redes LTE (em partes do mundo onde a tecnologia está disponível), além de uma câmera de 12 MP e 2 GB de RAM. Os dois últimos itens colocariam o aparelho da Samsung à frente dos modelos já mencionados, que tem câmeras de 8 MP e 1 GB de RAM.
E o geral o fato de que a Samsung produz quase todos os principais componentes de um smartphone, incluindo telas, processadores, memória Flash e RAM dá a empresa uma vantagem sobre os concorrentes, diz Malik Saadi, principal analista da Informa Telecoms & Media.
Saadi também espera que a Samsung lance uma versão 3G do aparelho, para regiões onde redes LTE não estão disponíveis (como o Brasil). Ele também deverá ser mais fino que seu antecessor.
O mercado de smartphones mudou, e a Apple e a Samsung o dominaram no ano passado. Durante os três últimos meses de 2011 elas tinham 47% do mercado, comparado a 26% no mesmo período do ano anterior, de acordo com números da Strategy Analytics.
A batalha entre as duas empresas irá continuar,e o Galaxy S III é importante porque será o segundo aparelho da Samsung que pode realmente competir com o iPhone, de acordo com Jeronimo.
“O Galaxy S II se saiu extremamente bem no mercado e foi o primeiro verdadeiro concorrente do iPhone. Estou interessado em ver como seu sucessor se sairá na tarefa”, disse Jeronimo
Tablets e ultrabooks serão 73% do mercado móvel em 2016
Segundo a Juniper Research, o Windows 8 terá um papel fundamental na adoção de ultrabooks e poderá impulsionar a adoção da tecnologia. Computerworld (Venezuela)
Um novo relatório da consultoria Juniper Research prevê que as vendas de dispositivos móveis, incluindo tablets, ultrabooks e notebooks, vão dobrar nos próximos cinco anos. Ultrabooks e tablets deverão conduzir esse crescimento, indica a Juniper, já que juntas as tecnologias vão ser responsáveis por 73% do mercado em 2016.
De acordo com a consultoria, serão comercializadas 178 milhões de unidades de ultrabooks, volume que indica que esse segmento saltará a uma ritmo três vezes superior ao dos tablets.
No entanto, as vendas de tablets no período serão uma das maiores registradas, atingindo 253 milhões de unidades. O Windows 8 será fundamental para formar esse cenário, aponta a Juniper. Isso porque, entre as características que compõem o novo sistema operacional da Microsoft estão a prorrogação da vida útil da bateria e a conectividade permanente com a internet.
O relatório também identificou que a consumerização está fazendo com que o computador tradicional seja visto como uma peça de museu, à medida que tablets, como o iPad, da Apple, e o Samsung Galaxy Tab, estão saindo da vida pessoal e invadindo a profissional.
Best Buy vai fechar 50 lojas nos Estados Unidos
Adrenaline / autor: risastoider
A Best Buy, uma das maiores redes de varejo dos Estados Unidos, amargou um prejuízo de US$1,7 bilhão no quarto trimestre fiscal e anunciou que vai fechar um total de 50 grandes lojas no país até o final do ano. Até então, a rede já havia encerrado as atividades em dois estabelecimentos e outras seis lojas já foram notificadas sobre o fechamento.
A expectativa é que a maior parte dessas lojas feche suas portas permanentemente a partir do dia 12 de maio.
“Essa não foi uma decisão fácil. Escolhemos as lojas cuidadosamente e estamos trabalhando para garantir que o impacto para nossos funcionários seja o menor possível, e também para atender aos nossos consumidores de uma maneira conveniente e satisfatória”, diz o comunicado oficial da Best Buy, que também lista todas as lojas que serão fechadas. “Mas nós também reconhecemos o impacto que essa notícia tem nas pessoas que merecem todo o respeito pelas contribuições que fizeram para o nosso negócio.”
Os planos da empresa incluem a abertura de novas lojas em um formato menor, especialmente dentro de shopping centers. A companhia ainda se comprometeu a fornecer maiores detalhes sobre essas ações no decorrer do ano.
Paralelamente, a rede segue em processo de seleção para um novo presidente-executivo. Na semana passada, Brian Dunn que, então, ocupava o cargo, resolveu pedir demissão abruptamente. Ele estava há menos de três anos no comando.
Tablet da Google será bem mais barato do que o iPad, garante CEO
PC World/US
A Google está disposta a inaugurar uma nova geração de tablets baratos, afirmou o CEO da empresa, Larry Page. Após observar o sucesso do Kindle Fire, que é fabricado pela Amazon, a gigante concluiu que há mais espaço no mercado para aparelhos mais em conta do que para postulantes a novo iPad.
Os tablets com Android não são tão populares quanto os smartphones da plataforma, que dominam mais da metade do setor. O iPad, disponível a partir de 400 dólares nos Estados Unidos, se mantém soberano enquanto seus rivais, da Samsung à RIM, lutam para igualar sua qualidade e seu preço.
No entanto, o Kindle Fire, que sai por 200 dólares, conseguiu rapidamente se tornar o segundo tablets mais popular. Com sete polegadas, ele possui uma versão customizada do Android que, de tão alterada, pouco parece com o SO original. Todos os serviços da Google, por exemplo, deram lugar aos da Amazon, como a loja de aplicativos e de conteúdo, em um modelo parecido com a da Apple, mas bem mais barato.
A Amazon vendeu mais de três milhões de unidades do seu aparelho em poucos meses, e a Google, claramente, tem consciência disso. Em resposta a um questionamento, durante reunião em que apresentou os resultados financeiros do trimestre, Page afirmou:
“Alguns tablets de baixo custo que rodam Android, embora não o modelo completo, conseguiram grande sucesso, e acreditamos que esse segmento ainda crescerá muito. É ele, definitivamente, que consideramos importante e em que estamos focados.”
A declaração do CEO reforça a última especulação de que agigante está se esforçando para lançar seu tablet em alguns meses e por um valor que não ultrapasse os 200 dólares. Ele também teria sete polegadas, contaria com Android 4.0 e processador de quatro núcleos, mas só se conectaria à rede Wi-fi.
De acordo com reportagem do portal The Verge, que ouviu fontes próximas à companhia de Mountain View, a Asus é que irá fabricar o tablet e não a Motorola. O valor sugerido seria de 250 dólares e, por isso, a Google adiou seu lançamento, a fim de chegar à meta dos 200 dólares.
Será interessante ver o esforço da empresa para diminuir o preço do produto. A Amazon foi obrigada a cortar recursos e oferecer um dispositivo com só 8GB de armazenamento interno, sem câmeras ou microfone, e com um design que muitos consideraram pouco atraente. Mesmo assim, suspeita-se que ela o esteja vendendo por um valor abaixo do que gasta para produzi-lo, na esperança de reverter o prejuízo com sua plataforma de conteúdo – aplicativos, músicas, vídeos e livros.
Por fim, Page falou do plano de fazer com que tablets e smartphone Android trabalhem melhor juntos. Segundo ele, o Google Play – que substituiu o Android Market – ajudará na tarefa. “Você não terá de gerenciar todos os dispositivos. Você, afinal, quer que todas essas telas à sua volta funcionem perfeitamente”.(Daniel Ionescu)
Porta retrato com Wi-Fi permite ouvir rádios e ver emails
A Sony lançou na última sexta-feira um porta retrato eletrônico com Wi-Fi embutido que permite ao usuário baixar fotos da internet, entrar no Facebook, ver emails, ouvir músicas em rádios via streamimg e até mesmo acessar serviços de previsão meteorológica.
O modelo DPF-WA700 tem display LED de 7" e memória interna de 1 GB. Além disso, também é capaz de rodar vídeos em HD no formato MPEG-4. O dispositivo ainda conta com diversas entradas para cartões de memória SD, SDHC, SDX e outros.
As rádios podem ser acessadas e tocadas por um speaker embutido no porta retrato. Segundo a Sony, o produto poderá ser sincronizado com o PlayMemories, aplicativo da empresa para retoque de fotos e vídeos.
Os serviços de previsão meteorológica serão possíveis graças a uma parceria com a empresa AccuWeather. O preço do produto nos Estados Unidos é de US$ 160. HT On Line
4G deve custar o dobro do atual 3G no Brasil
O preço dos planos de internet 4G no Brasil deverão custar o dobro do que as operadoras cobram atualmente pela tecnologia 3G. O motivo é o alto investimento que as teles deverão fazer para viabilizar as conexões mais rápidas em dispositivos móveis, de acordo com o jornal O Globo.
As primeiras redes comerciais 4G devem começar a operar em abril de 2013 nas cidades brasileiras que receberão jogos da Copa das Confederações. O SindiTelebrasil, sindicato do setor, acredita que o prazo é muito curto - o leilão da frequência deve ser feito em junho, o que daria menos de um ano para as teles implantarem a tecnologia.
Quando estiver funcionando, a internet móvel de quarta geração permitirá a transmissão de vídeos em alta resolução, o que é importante para eventos esportivos de grande porte, como a própria Copa das Confederações e a Copa do Mundo de 2014.
O problema é que, para fazer a rede funcionar, as teles terão que investir bilhões. "Será preciso modernizar 60% das linhas de transmissão do país. O 3G pode usar o cabo da 2G, mas o 4G não, pois demanda mais capacidade", afirma Erasmo Rojas, presidente da 4G Americas.
Devido ao alto investimento feito pelas operadoras, o consumidor final deve receber um preço elevado para ter uma conexão 4G - de acordo com estimativas do SindiTelebrasil, será, no mínimo, o dobro do valor cobrado pelo 3G atualmente. Olhar Digital.
Anatel autoriza venda do novo iPad no Brasil
O novo iPad pode estar mais perto de ser lançado no Brasil. O certificado de homolagação dos modelos A1416 e A1430 do tablet foi emitido na última sexta-feira (13/04) pela Agência Nacional de Telecomunicações, a Anatel, o que autoriza a venda do produto em solo nacional.
De acordo com os documentos publicados no Sistema de Gestão de Certificação de Homologação da Anatel, o aparelho será produzido em duas fábricas da Foxconn: uma em Jundiaí, São Paulo, e outra na província de Shenzen, China.
A homologação também detalha a compatibilidade de ambos os modelos com Wi-Fi (A1416) e as redes 3G e 4G (A1430), mas ainda não se sabe se a opção de quarta geração chegará ao país devido à incompatibilidade da rede 4G brasileira (2,5 GHz). Contudo, todas as variantes do dispositivo - 16 GB, 32 GB e 64 GB - foram certificadas.
Isso significa que a Apple pode fazer o lançamento do novo iPad em território brasileiro a qualquer momento. A data para início das vendas, no entanto, ainda não foi divulgada.
O novo iPad, anunciado no início de março por Tim Cook, traz como principal novidade a tela retina com resolução de 2048x1536, além de conexão 4G (LTE), processador gráfico quad-core, gravação de vídeos em 1080p e o sistema operacional iOS 5. Até agora, já foram vendidos mais de 3 milhões de aparelhos em todo o mundo. Olhar Digital.
sexta-feira, 13 de abril de 2012
Protótipo de Mac antigo, de 1982, está à venda no eBay
Gosta de raridades e antiguidades? Um protótipo de um Macintosh, produzido entre 1982 e 1983, está à venda no Ebay para quem estiver disposto a gastar US$100 mil (cerca de R$180 mil).
O computador é um Macintosh modelo 128k, que foi originalmente projetado para carregar o "Twiggy", drive de disquete de 13 centímetros. Porém, devido à quantidade de problemas apresentados, ele foi substituído por um drive da Sony de 9 cm apenas 3 meses antes de seu lançamento.
Ele é o que o "wozniac", nickname do usuário do Canadá responsável pela venda do produto, chama de "o mais velho Mac completo", já que "apenas pedaços e peças do original Macintosh com drive Twiggy foram exibidos até hoje". Ele explica que placas-mãe e cases de plástico já foram oferecidos no mercado, mas nunca uma máquina completa. Segundo o vendedor, a que está à venda "é a única".
Quem arrematar o produto, levará o protótipo do computador além do teclado, mouse e cabo de energia, todos funcionando. Segundo o vendedor, o computador liga e a tela cinza com o pedido de inserção de disquete aparece.
Para quem quiser adquirir a raridade, além dos US$100 mil, há um frete de US$1,5 mil (cerca de R$2,7 mil), entregando também para o Brasil. E aí, vai encarar essa? por Olhar Digital.
Veja como “ejetar” um pendrive ou HD externo teimoso
Lincoln Spector, PCWorld EUA
Ao terminar de usar um pendrive ou HD externo num PC com Windows, o correto é clicar sobre seu ícone com o botão direito do mouse e escolher a opção “Ejetar” antes de simplesmente desplugar o acessório da máquina. Assim você dá ao sistema a chance de fechar quaisquer arquivos no drive que ainda estejam sendo acessados, e evita a corrupção de dados.
Mas às vezes parece que o Windows “se apega” ao drive e, em vez de dizer que “O hardware pode ser removido com segurança” ele diz que “Este dispositivo está sendo usado no momento. Feche os programas ou janelas que possam estar usando o dispositivo e tente novamente”. Ou seja, o sistema se recusa a ejetar o dispositivo.
A primeira coisa que você deve fazer é seguir a sugestão do sistema. Dê uma olhada na barra de tarefas ou na bandeja do sistema (a área ao lado do relógio) e veja se não há nenhum arquivo do pendrive aberto em algum programa. Fechar o arquivo geralmente resolve o problema.
Se não houver nenhum arquivo ainda aberto, tente fechar programas que já acessaram algum arquivo do pendrive, mesmo que não estejam acessando mais. Por exemplo, uma vez eu estava editando um documento do Word armazenado em um pendrive, e tive de fechar o Word inteiro, e não só o arquivo, para poder ejetar o pendrive. Fechar janelas do Windows Explorer também pode ajudar.
Se nenhuma destas dicas funcionar, o jeito é apelar para o processo mais demorado: desligue o PC, desconecte o pendrive e ligue o PC de novo.
Mas se o problema acontece com frequência, tente baixar e instalar o Unlocker, disponível gratuitamente em versões para sistemas de 32 ou 64 Bits. Preste atenção ao instalá-lo e rejeite as ofertas de software extra que vem junto, como a Bing Bar.
O programa foi projetado para auxiliar na exclusão de arquivos que o Windows não permite que sejam apagados porque estão em uso, mas também ajuda na remoção de drives. Se o Windows não lhe disser que o hardware pode ser removido com segurança, clique com o botão direito do mouse sobre o ícone do drive na janela Computador e escolha a opção Unlocker no menu. Ele vai mostrar uma janela com todos os programas e processos em andamento que estão acessando o drive.
O Unlocker tem botões como Kill Process e Unlock, que permitem forçar o encerramento de um programa ou processo e então “liberar” o arquivo para exclusão. Mas não precisa ser bruto: simplesmente anote o nome do programa que está acessando o drive e feche-o normalmente.
Tablets Transformer Pad 300 da ASUS são listados em lojas internacionais
autor: carolina (adrenaline)
Enquanto a companhia ASUS anunciou no mês de fevereiro a sua nova série de híbridos entre tablets e netbooks – a Transformer Pad 300 –, até o momento nenhuma data oficial de lançamento foi divulgada pela empresa, de acordo com o site TecMundo.
Enquanto isso, a equipe do site Android Community encontrou uma listagem do modelo de 32 GB no site da loja online francesa Tablette Store por 499 euros (cerca de R$ 1.200, de acordo com a cotação atual), com previsão de lançamento para o dia 15 de maio.
Já o site The Verge descobriu que a loja norte-americana J&R deve vender o modelo de 16 GB por US$ 379 (cerca de R$ 700, segundo a cotação do dia). Embora o produto ainda não esteja listado no site oficial da empresa, a confirmação foi feita por um representante de vendas da rede.
A série de tablets Transformer Pad 300 apresenta as seguintes especificações técnicas:
- Processador quad-core NVIDIA Tegra3 SoC
- Tela de 10,1 polegadas com resolução 1280x800
- 1 Gb de memória RAM
- Câmera traseira de 8 megapixel
Já o teclado acoplável será vendido separadamente e deve ser vendido, de acordo com a J&R, por US$ 149 (R$ 270). Todos os valores descritos, no entanto, ainda não foram confirmados oficialmente pela ASUS.
Nova Sony irá investir pesado em dispositivos móveis
Logo após assumir como presidente-executivo da Sony Corporation, Kazuo Hirai apresentou ontem a estratégia para recuperar a empresa, que terá como base os dispositivos eletrônicos moveis: celulares, videogames e câmeras, além de uma divisão de equipamentos hospitalares com vendas anuais de 1,2 bilhão de dólares.
Além de anunciar investimentos em novas áreas, o presidente deverá promover o corte de cerca de 10 mil postos de trabalho em todo o mundo no atual ano fiscal, na tentativa de reverter os fortes prejuízos que a empresa vem sofrendo, decorrentes principalmente da unidade de televisores.
Hirai, que substituiu Howard Stringer este mês, dobrou a projeção de prejuízo anual da Sony, para o recorde de 6,4 bilhões de dólares, e está sob intensa pressão para resolver os problemas da deficitária divisão de televisores, em meio à crise vivida pela companhia que vem sofrendo graves derrotas diante da Apple e da sul-coreana Samsung Electronics.
A Sony e outras fabricantes japonesas de televisores, como Sharp e Panasonic, vêm sendo prejudicadas por fatores como demanda fraca, concorrência maior e iene mais forte, tornando as exportações menos competitivas.
As três empresas devem anunciar prejuízo combinado superior a 21 bilhões de dólares para o ano fiscal encerrado em 31 de março, o que supera o valor de mercado da Sony, que diminuiu em mais de 20% no último mês.
A Samsung tem valor de mercado dez vezes mais alto, e a Apple, que executivos da companhia japonesa consideraram adquirir nos anos 90, hoje vale 30 vezes mais que a Sony.
Além da demissão de 10 mil funcionários, ou 6% do quadro mundial da empresa, a Sony afirmou que irá contabilizar provisão de 75 bilhões de ienes (926 milhões de dólares) para reestruturação no ano fiscal até março de 2013.
Fonte: Reuters e Sony (HT On Line)
Lenovo aumenta vantagem sobre a Dell no mercado de PCs
Fabricante chinesa cresceu 43,7% no primeiro trimestre deste ano e HP, apenas 3,2%. Setor avançou 2,3%, contrariando as expectativas da IDC.
A Lenovo aumentou sua vantagem sobre a Dell no mercado de computadores pessoais, mas ainda é cedo para saber se ela é candidata a roubar a liderança da HP, informou a consultoria IDC na última nesta semana.
O crescimento da Lenovo é atribuído ao seu bom resultado na Ásia e à sua expansão nas Américas e na Europa. Suas vendas aumentaram 43,7% na comparação do primeiro trimestre de 2012 em relação ao mesmo período do ano passado, atingindo 11,7 milhões de unidades entregues. As da Dell, por outro lado, caíram 2,1%.
Desta forma, a fabricante chinesa conquistou 13,4% do setor nos três primeiros meses deste ano, se aproximando da HP, que obteve 18% - crescimento de 3,2% em relação ao primeiro trimestre de 2011 - e se distanciando da Dell, que ficou com 11,6%. Vale lembra que, caso os tablets sejam considerados PCs, a Apple assume a primeira colocação.
Para Jay Chou, analista da IDC, embora a HP tenha se recuperado ela terá de fazer mais para impedir que a Lenovo tome seu lugar.
“A HP é indiscutivelmente mais forte na área comercial, o que será importante quando a economia voltar a crescer e as companhias começarem a gastar mais”, afirmou.
Ao todo, o mercado de computadores pessoais avançou 2,3% frente ao primeiro trimestre do ano passado, alcançando 87 milhões de unidades comercializadas e superando as expectativas do instituto, que esperava uma queda de 0,9%. A tendência é que as vendas ganhem novo impulso no final do ano, graças ao lançamento do Windows 8, que deve ocorrer em outubro. Agam Shah, do IDG News Service (Computerworld).
Rival do iPad: Intel prepara tablets Windows 8 com mais 10 fabricantes
Durante conferência, executivo da empresa disse que primeiro smartphone com chip Intel, o K800 da Lenovo, deve ser lançado no final de maio.Por IDG News Service
A fabricante de processadores Intel anunciou que está trabalhando com 10 empresas chinesas, não reveladas, e fornecedores mundiais para fazer o projeto dos tablets com sistema Windows 8 que usarão os chips Intel, informou um executivo sênior da companhia. "Vocês provavelmente verão os tablets chegando ao mercado no final deste ano", disse o diretor Sean Maloney, ao falar no Fórum de Desenvolvedores da Intel em Pequim, na China.
Maloney comentou que Intel está trabalhando para expandir seu mercado para smartphones e tablets. O novo processador Atom da empresa, o Z2460 - conhecido como "Medfield", foi projetado para os dispositivos móveis e promete oferecer maior desempenho de computação e longa durabilidade de bateria.
O Medfield será usado no aparelho K800, da chinesa Lenovo, o primeiro smartphone a usar a tecnologia. O produto deve ser lançado no final de maio deste ano, segundo o vice presidente da companhia, Wayne Chen. A parcela de mercado da Lenovo no ano passado foi menor que 5%, de acordo com a firma de análises Canalys. O K800 será posicionado como um aparelho "top de linha", disse Maloney.
A Intel também está desenvolvendo outro processador para dispositivos móveis, chamado Clover Trail, projetado para tablets e também deve estar disponível no mercado neste ano. Maloney declarou que o chip terá 1.8 GHz.
Embora a Intel seja o maior nome no segmento de processadores para PC, as ambições da empresa são grandes, especialmente na China. "Nossa estratégia agora é vencer nos mercados de smartphones e tablets. Estamos progredindo com isso!", afirmou Maloney nesta semana durante um bate-papo com internautas.
A fabricante chinesa ZTE também planeja lançar chips no segundo semestre de 2012, informou Maloney.
A Intel está projetando mais dois processadores para smartphones. O Atom Z2580 vai oferecer um desempenho duas vezes melhor que o pioneiro Medfield; e o Atom Z2000 terá 1.0 GHz e será usado em aparelhos mais básicos.
Assinar:
Comentários (Atom)